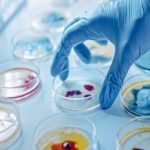
Microbiology

Diagnostic center in Padmanabhanagar
Started by a group of like-minded and service-oriented doctors in February 2008, Acura is a well-known name around Padmanabhanagar and Uttarahalli in the field of diagnostics and high-end Sonography. We are recognized for offering the Diagnostic center in Padmanabhanagar.
Our main motto is to provide quality and reliable diagnostic/clinical services at affordable rates. With over 15 years of experience in this field, Acura has built a strong loyal customer base that thrives on outstanding quality and unparalleled services.
Our team of dedicated and well-trained professional staff, backed by highly experienced and knowledgeable specialist doctors armed with high-end machines, play a vital role in the trust of our patients.
Ultrasonography Services





Laboratory/Pathology Services

TESTIMONIALS
Great place for scanning.I thank radiologists for their patience and efforts. Even though long waiting was required, their reports are very accurate and we are very much satisfied with thier explanation and care towards patients. Definately recommend if you are looking for good reports



